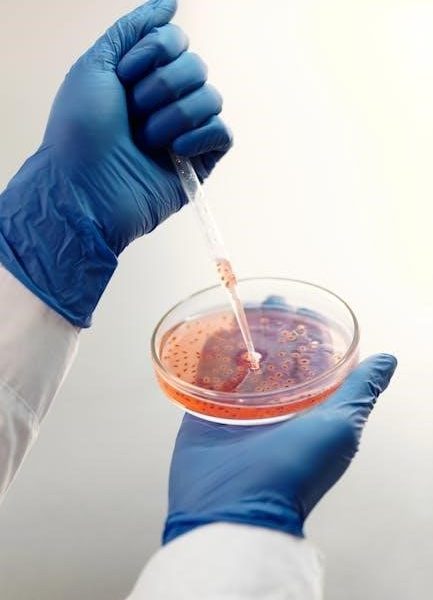

Bacterial identification, exemplified by reports analyzing unknown bacteria (often found as a PDF), is crucial for medical, environmental, and research contexts.
Purpose of Identification
The core purpose of identifying unknown bacteria, documented in a lab report (often a PDF), extends beyond simple categorization. Accurate identification is fundamental for understanding a microorganism’s role in disease, environmental processes, or industrial applications. Determining bacterial species informs appropriate treatment strategies for infections, guides public health interventions, and aids in monitoring environmental quality.
Furthermore, precise identification is vital for research, enabling scientists to study bacterial physiology, genetics, and evolution. A comprehensive lab report detailing the identification process ensures reproducibility and facilitates knowledge sharing within the scientific community.
Importance of Accurate Identification
Accurate bacterial identification, meticulously detailed in an unknown bacteria lab report (typically a PDF), is paramount for effective decision-making. Misidentification can lead to inappropriate antibiotic prescriptions, ineffective infection control measures, and compromised patient outcomes. In environmental microbiology, errors can result in flawed assessments of water or food safety.
Beyond healthcare, correct identification is crucial for industrial processes like fermentation and bioremediation. A precise report ensures reliable results, preventing costly errors and maintaining product quality. Thorough documentation builds confidence in findings and supports informed scientific conclusions.

Sample Collection and Preparation
Proper sample handling is vital for an unknown bacteria identification lab report (PDF). Collection methods and preparation directly impact accurate results.
Proper Collection Techniques
Obtaining a representative sample is paramount when preparing an unknown bacteria identification lab report (PDF). Sterile swabs, loops, or needles should be used, depending on the source – liquid, solid, or surface.
Avoid contamination by ensuring the collection site isn’t compromised before sampling. For clinical specimens, follow established protocols regarding site preparation and collection volume. Accurate labeling with date, time, source, and patient information is essential for traceability.
Transport samples promptly to the lab, utilizing appropriate transport media to maintain viability and prevent overgrowth of unwanted organisms.
Sterile Techniques and Contamination Prevention
Maintaining sterility is vital when preparing an unknown bacteria identification lab report (PDF). All media, tools (loops, needles), and work surfaces must be sterilized via autoclaving or appropriate disinfection.
Employ aseptic transfer techniques – flaming loops before and after use, minimizing exposure of cultures to air, and working near a flame create a sterile field.
Proper hand hygiene and wearing gloves prevent introducing external contaminants. Regularly disinfect work areas and promptly address any spills to avoid cross-contamination, ensuring accurate results.
Initial Sample Observation (Macroscopic)
Macroscopic examination forms the first step in an unknown bacteria identification lab report (PDF). Observe the sample’s physical characteristics – color, texture (smooth, rough, mucoid), and morphology of colonies on agar plates.
Note colony shape (circular, irregular), margin (entire, lobate), elevation (flat, raised), and any pigment production.
Record observations of growth patterns – confluent, discrete – and any visible zones of hemolysis on blood agar. These initial observations guide subsequent microscopic and biochemical tests.

Microscopic Examination
Microscopic analysis, detailed in an unknown bacteria lab report (PDF), reveals crucial cellular details like shape, arrangement, and staining characteristics for identification.
Gram Staining Procedure
Gram staining, a cornerstone of unknown bacteria identification (documented in a lab report PDF), differentiates bacteria based on cell wall structure. The procedure involves crystal violet, Gram’s iodine, decolorization (typically with alcohol), and safranin counterstain.
Gram-positive bacteria retain the crystal violet dye, appearing purple, due to a thick peptidoglycan layer. Gram-negative bacteria, with a thinner layer and outer membrane, lose the crystal violet during decolorization and are stained pink by safranin. Accurate execution and interpretation are vital for correct bacterial classification and further testing.
Cell Morphology and Arrangement
Observing cell morphology and arrangement is fundamental when identifying unknown bacteria, detailed within a lab report PDF. Microscopic examination reveals bacterial shape – cocci (spherical), bacilli (rod-shaped), or spirilla (spiral).
Arrangement patterns, such as single cells, pairs (diplococci/diplobacilli), chains (streptococci/streptobacilli), or clusters (staphylococci), provide further clues. These characteristics, combined with Gram stain results, narrow down possibilities and guide subsequent biochemical tests for accurate identification.
Capsule Staining
Capsule staining, documented in an unknown bacteria identification lab report PDF, determines if a bacterium possesses a protective capsule layer. This technique utilizes acidic dyes that stain the background, while the capsule remains clear due to its non-affinity for most stains.
Capsule presence aids in identifying virulent strains, as capsules often protect bacteria from phagocytosis. Observing capsule size and shape contributes to species differentiation, offering valuable insights alongside other morphological and biochemical data.
Biochemical Testing
Biochemical tests, detailed in an unknown bacteria lab report PDF, assess metabolic capabilities, crucial for differentiating bacteria based on enzymatic activities.
Catalase Test
The catalase test, a fundamental component of an unknown bacteria identification lab report PDF, determines the presence of the catalase enzyme. This enzyme catalyzes the breakdown of hydrogen peroxide (H2O2) into water and oxygen. A positive result, indicated by immediate bubbling, signifies the bacterium possesses catalase, protecting it from reactive oxygen species.
Conversely, a negative result—no bubbles—suggests the absence of catalase. This test is particularly useful in differentiating staphylococci (catalase-positive) from streptococci (catalase-negative), aiding in narrowing down potential bacterial identities within the report.
Oxidase Test
The oxidase test, vital for an unknown bacteria identification lab report PDF, detects the presence of cytochrome c oxidase. This enzyme participates in the electron transport chain within some bacteria. The test utilizes a reagent that mimics cytochrome c; a positive result is indicated by a rapid color change (typically purple/blue) signifying the enzyme’s presence.
A negative result, no color change, suggests the bacterium lacks cytochrome c oxidase. This test is crucial for differentiating genera like Pseudomonas (oxidase-positive) from Enterobacteriaceae (oxidase-negative), streamlining identification.
Sugar Fermentation Tests (e.g., Glucose, Lactose)
Sugar fermentation tests, essential for an unknown bacteria identification lab report PDF, determine a bacterium’s ability to metabolize specific sugars like glucose and lactose. These tests utilize a phenol red indicator; acid production (fermentation) causes a color change to yellow, while alkalinity remains red.
Differentiation between E. coli (lactose-positive) and Salmonella (lactose-negative) exemplifies their utility. Gas production, indicated by bubbles, is also noted, aiding in precise species identification and report completion.
Motility Testing
Motility testing is a key component of an unknown bacteria identification lab report PDF, determining a bacterium’s ability to move independently. Several methods exist, including soft agar stabs and hanging drop slides. Growth radiating from the stab line in soft agar indicates motility.
Observing bacterial movement under a microscope using a hanging drop confirms this. Motility is a crucial characteristic for differentiating between genera and species, contributing significantly to accurate identification and detailed report documentation.
Indole Test
The Indole Test, vital for an unknown bacteria identification lab report PDF, detects the presence of tryptophanase. This enzyme breaks down tryptophan into indole. Bacteria are inoculated into tryptophan broth; a positive result shows a red layer after adding Kovac’s reagent, indicating indole production.
This test differentiates Gram-negative bacteria, particularly Enterobacteriaceae. A clear report meticulously documents the procedure, observations, and interpretation, aiding in precise species identification and comprehensive analysis.
Methyl Red and Voges-Proskauer Tests
Methyl Red (MR) and Voges-Proskauer (VP) tests, essential for an unknown bacteria identification lab report PDF, differentiate bacteria based on acid and acetoin production from glucose fermentation. MR tests detect mixed acid fermentation (red at pH < 4.4), while VP tests identify acetoin (pink color change).
These tests are often performed together to distinguish between different Enterobacteriaceae genera. Accurate documentation of results is crucial for a comprehensive and reliable bacterial identification process.
Citrate Utilization Test
The Citrate Utilization Test is a key component of an unknown bacteria identification lab report PDF, determining a bacterium’s ability to use citrate as its sole carbon source. This is assessed using Simmon’s citrate agar, where growth and a color change from green to blue indicate positive citrate utilization.
This test helps differentiate bacteria within the Enterobacteriaceae family and is vital for narrowing down possibilities during identification, providing crucial data for accurate classification.

Differential and Selective Media
Differential and selective media, like MacConkey and Blood Agar, are essential tools in an unknown bacteria identification lab report PDF for isolating and characterizing microbes.
MacConkey Agar
MacConkey Agar is a crucial selective and differential medium utilized extensively in unknown bacteria identification, frequently documented within a lab report PDF. It selectively grows Gram-negative bacteria, inhibiting the growth of Gram-positive organisms due to the presence of bile salts and crystal violet.
Furthermore, it differentiates bacteria based on their ability to ferment lactose. Lactose fermenters produce acidic end products, causing the pH indicator to turn colonies pink or red, while non-fermenters remain colorless. Observing colony morphology and lactose fermentation patterns on MacConkey Agar provides vital clues for bacterial identification, aiding in narrowing down possibilities within the report.
Blood Agar
Blood Agar serves as both a rich, differential medium and is a cornerstone in unknown bacteria identification, commonly detailed in a lab report PDF. It supports the growth of many bacterial species, but its key feature lies in detecting hemolytic activity.
Hemolysis, the lysis of red blood cells, is categorized as alpha (partial), beta (complete), or gamma (no) hemolysis, visualized as distinct zones around colonies. This characteristic aids in differentiating species like Streptococcus and Staphylococcus, providing crucial data for accurate identification documented within the comprehensive lab report.
Mannitol Salt Agar
Mannitol Salt Agar (MSA) is a selective and differential medium vital for identifying unknown bacteria, frequently detailed within a lab report PDF. Its high salt concentration (7.5% NaCl) inhibits most bacteria except halotolerant ones, notably Staphylococcus species.
MSA differentiates Staphylococcus aureus from other staphylococci based on mannitol fermentation. S. aureus ferments mannitol, producing acid and changing the pH indicator, resulting in a yellow zone around colonies. This crucial observation, documented in the report, aids in precise bacterial identification.

Advanced Identification Techniques
Advanced methods, like API strips and 16S rRNA sequencing, provide precise unknown bacteria identification, often supplementing data within a comprehensive lab report PDF.
API Strips and Automated Systems
Analytical Profile Index (API) strips represent a miniaturized biochemical test system, streamlining unknown bacteria identification. These strips contain dehydrated media for various metabolic tests; results are compared to database profiles.
Automated systems, building upon API technology, offer increased throughput and reduced subjectivity. They rapidly analyze multiple biochemical reactions, generating identification probabilities.
Both methods significantly accelerate the process detailed in a typical unknown bacteria lab report PDF, providing a more efficient and standardized approach to microbial characterization, crucial for accurate diagnoses.
Molecular Methods (16S rRNA Sequencing)
16S rRNA sequencing represents a gold standard for bacterial identification, particularly for unknown bacteria detailed in a lab report PDF. This technique analyzes the highly conserved 16S ribosomal RNA gene, possessing both conserved and variable regions.
PCR amplification and sequencing of this gene allow comparison to extensive databases, revealing phylogenetic relationships and species-level identification.
It overcomes limitations of biochemical tests, offering higher accuracy and the ability to identify even closely related species, providing definitive results for complex microbial analyses.

Interpreting Results and Creating a Lab Report
Analyzing data from unknown bacteria (often in a PDF report) requires careful interpretation of tests, leading to a conclusive identification and detailed discussion.
Data Organization and Presentation
Effective lab reports detailing unknown bacteria identification (typically a PDF document) demand meticulous data organization. Tables should clearly present biochemical test results – catalase, oxidase, fermentation profiles – alongside media observations like growth on MacConkey or Blood Agar.
Figures, such as Gram stain images, illustrate cell morphology and arrangement. A flowchart visually mapping the identification process enhances clarity. Consistent formatting, proper labeling, and concise captions are essential. Statistical analysis, if applicable, should be included, bolstering the report’s scientific rigor and interpretability.
Flowchart for Identification
A crucial component of an unknown bacteria identification lab report (often a PDF) is a clear flowchart. This visual guide begins with initial observations – Gram stain, morphology – then branches based on biochemical test results.
Positive or negative reactions for catalase, oxidase, and sugar fermentation dictate subsequent tests. The flowchart should illustrate decision points, leading to differential media selection and ultimately, probable genus and species identification. It streamlines the process, demonstrating logical deduction and efficient analysis.
Discussion of Potential Errors
A comprehensive unknown bacteria identification lab report (often a PDF) must address potential errors. Contamination during sampling or staining can yield inaccurate results. Misinterpretation of biochemical tests, or using outdated media, introduces further uncertainty.
Variations within bacterial species can lead to ambiguous profiles. The report should acknowledge these limitations, suggesting further testing or acknowledging the possibility of inconclusive identification. Thorough error analysis demonstrates critical thinking and scientific rigor.

Report Structure and Content
A typical unknown bacteria lab report (often a PDF) includes title, author details, methods, results – presented via tables/figures – and a conclusive identification.
Title and Author Information
The title of your unknown bacteria identification lab report should be concise yet descriptive, accurately reflecting the experiment’s purpose – for example, “Identification of an Unknown Bacterial Isolate.” Crucially, include your full name, student ID, and the date of submission prominently on the report’s title page.
Additionally, specify the course name and instructor’s name. A properly formatted title page establishes professionalism and facilitates easy identification of the report’s origin. Many institutions require a specific format for this section, often detailed in the lab manual or syllabus; adhere to these guidelines meticulously when preparing your PDF document.
Materials and Methods Section
Detailing materials used in your unknown bacteria identification (for your PDF report) is vital. List all media (MacConkey, Blood Agar), stains (Gram stain reagents), biochemical tests (catalase, oxidase), and equipment (microscopes, incubators).
Methods should be a chronological, step-by-step account of procedures. Include incubation temperatures and times. Use passive voice (“The sample was Gram stained”) and sufficient detail for reproducibility. Cite any standard protocols followed. Clarity and precision are paramount in this section, ensuring others can replicate your work accurately.
Results Section (Tables and Figures)
Presenting results from your unknown bacteria identification (within your PDF report) requires clarity. Utilize tables to summarize biochemical test outcomes (catalase, oxidase, fermentation). Figures should display microscopic observations – Gram stain morphology, colony characteristics on agar plates.
Avoid interpretation here; simply report observations. Label tables and figures clearly. Refer to them within the text (“As shown in Table 1…”). Ensure data is presented logically and concisely, allowing readers to easily grasp the findings supporting your eventual identification.
Based on the accumulated data from biochemical tests, microscopic examinations, and media observations (detailed in your unknown bacteria PDF report), state your final bacterial identification. Justify this conclusion, explicitly linking results to key characteristics of the identified species.
Address any discrepancies or limitations encountered during the identification process. Discuss potential sources of error. Clearly state the level of certainty regarding your identification – is it definitive, or a probable match?

Safety Considerations
Handling unknown bacteria (as detailed in the lab report PDF) requires strict adherence to biosafety protocols, including proper sterilization and disposal procedures.
Biosafety Levels and Precautions
Working with unknown bacteria, documented in a typical lab report PDF, necessitates understanding biosafety levels. Most introductory labs utilize Biosafety Level 1 (BSL-1), requiring standard microbiological practices.
However, potential pathogens demand BSL-2, adding precautions like lab coats, gloves, and eye protection. Always decontaminate work surfaces before and after use.
Proper handling of cultures, avoiding aerosol creation, and immediate reporting of spills are vital. Autoclaving all materials post-experiment ensures safe disposal, minimizing environmental contamination risks.
Proper Disposal of Cultures
Following bacterial identification, detailed in a lab report PDF, safe culture disposal is paramount. Autoclaving is the primary method, effectively sterilizing all bacterial waste – plates, tubes, and liquids – before disposal.
Never discard cultures directly into regular trash. Liquid cultures should be treated with disinfectant before autoclaving.
Sharps, like needles or broken glass contaminated with bacteria, require separate, puncture-proof containers. Adhering to institutional guidelines and local regulations ensures environmental safety and prevents potential contamination.
Resources and Further Learning
Explore online databases like NCBI and textbooks for bacterial identification techniques, enhancing understanding of lab report analysis (PDF format).
Relevant Websites and Databases
For comprehensive bacterial identification resources, explore the National Center for Biotechnology Information (NCBI) website, offering extensive genomic data and taxonomic information crucial for analyzing unknown bacteria. The Bergey’s Manual of Determinative Bacteriology, available through various library databases, provides detailed identification schemes.
Additionally, the Centers for Disease Control and Prevention (CDC) offers valuable information on bacterial pathogens and identification protocols. Accessing publicly available lab report examples (often in PDF format) can aid in understanding report structure and interpretation. Consider utilizing online bacterial identification keys and interactive tools for practice.
Recommended Textbooks and Publications
Bergey’s Manual of Determinative Bacteriology remains the gold standard for taxonomic identification. Supplement these with journal articles from the Journal of Clinical Microbiology and International Journal of Systematic and Evolutionary Microbiology for current research and advanced techniques.